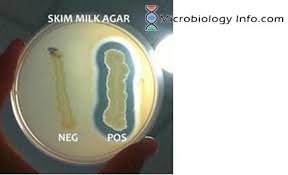
<p>Skim milk agar test</p>
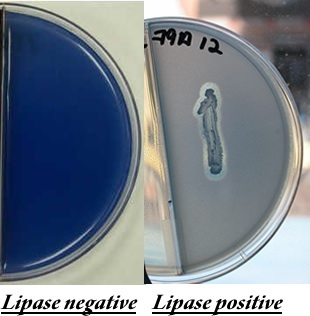
<p>Spirit blue agar test</p>

Micro lab practical
1/43
There's no tags or description
Looks like no tags are added yet.
Name | Mastery | Learn | Test | Matching | Spaced | Call with Kai |
|---|
No analytics yet
Send a link to your students to track their progress
44 Terms

Glucose, Lactose, and Mannitol fermentation tests
Glucose
ferment glucose to produce acidic and gaseous end products
Lactose
ferment the sugar lactose to produce acidic and gaseous end products
Mannitol
ferment the sugar alcohol mannitol, producing acidic and gaseous end products
(+) = yellow acid and maybe gas
G, L, or M —→ fermentation —→ acid/gas

Oxidase Test
determines if a bacterium produces the enzyme cytochrome c oxidase, which is part of its electron transport chain
(+) = blue

Catalase test
determines if a bacterium produces the enzyme catalase, which breaks down toxic hydrogen peroxide into water and oxygen,
(+) = bubbles
H2O2 —→ via catalase —→ H2O + Oxygen

Nitrate reduction test
determine if bacteria can utilize nitrate as an electron acceptor during anaerobic respiration, specifically by producing the enzyme nitrate reductase to convert nitrate into nitrite
(+) = red
Nitrate —→ via nitrate reductase —→ nitrite

Indole test
determines the ability of bacteria to produce the enzyme tryptophanase, which breaks down the amino acid tryptophan into indole
(+) = red
Tryptophn —→ via tryptophanase —→ indole

Methyl red test
determines if bacteria perform mixed-acid fermentation, producing stable, high-concentration acid end-products from glucose
(+) = red
Glucose —→ via mixed-acid ferm. —→ acid

Vogues-Proskauer test
detects acetoin (acetylmethylcarbinol), a neutral byproduct produced during the fermentation of glucose via the 2,3-butanediol pathway
(+) = red
Glucose —→ via fermentation —→ acetoin

citrate test
determines if a bacterium can use citrate as its sole carbon source and ammonium salts as its sole nitrogen source
It specifically tests for the enzyme citrate permease,
(+) = blue

Starch agar test
determines if a microorganism produces extracellular enzymes, specifically amylase and oligo-1,6-glucosidase
(+) = halo
Skim milk agar test
to detect if microorganisms produce extracellular enzymes, specifically caseinase, which break down the milk protein casein
(+) = halo
Spirit blue agar test
to detect and identify microorganisms that produce the enzyme lipase, which breaks down lipids (fats) into fatty acids and glycerol.
(+) = halo
Lipids —→ via lipase —→ glycerol + fatty acids

Urea agar test
to differentiate microorganisms based on their ability to produce the enzyme urease, which hydrolyzes urea into ammonia and carbon dioxide
(+) = pink
urea —→ via urease —→ ammonia + CO2

Kligers iron agar test
Kligler’s Iron Agar (KIA) is used to differentiate Gram-negative enteric bacilli by detecting their ability to ferment glucose (dextrose) and lactose, produce hydrogen sulfide, and produce gas
Yellow (A)→ Acidic (fermentation)
Red (K)→ Alkaline (no fermentation, peptone use)
Black→ H₂S hydrogen sulfide

Motility test
to determine if bacteria can move independently using flagella

Colony morphology
the visual characteristics of bacterial or fungal colonies grown on agar plates

Agar slant growth
describes the visual appearance of bacterial growth along the inoculated line, used for identification

Protease production (gelatin slab)
identifies microorganisms that produce extracellular gelatinases, which hydrolyze gelatin into amino acids, causing liquefaction
(+) = liquid

Oxygen requirements
Obligate aerobes - Growth exclusively at the top of the tube, where oxygen concentration is high
Obligate anaerobes - Growth only at the very bottom, where oxygen is absent
Facultative anaerobes - Growth throughout the tube, but usually with a higher concentration near the top.
Aerotolerant anaerobes - uniform growth throughout tube as they do not use oxygen but are not harmed by it
Microaerophiles - Growth in a thin band just below the surface, requiring low levels of oxygen

Gram stain
Distinguishes between Gram-positive (thick peptidoglycan layer) and Gram-negative (thin layer) bacteria.
(+) = purple

acid fast stain
It works by staining wax-like, mycolic acid-rich cell walls red with carbolfuchsin, which resists decolorization by acid-alcohol, unlike non-acid-fast bacteria.
(+) = pink
Bacteria used in capsule stain
K. pneumoniae
Function of capsule
protection and attatchment
Step excluded in the capsule stain
heat fixation (it will destroy the capsules)
Bacteria used in UV experiment
S. aureus and B. cereus
Grows unexposed to UV light
S. aureus
Growth exposed and unexposed to UV light
B. cereus (endospores)
Bacteria used in salt concentration experiments
E. coli, S. aureus. H. salinarium
Will not thrive in a salty environment (non-halophile)
E. coli
Will grow in low or high salt concentration (Halotolerant bacteria)
S. aureus
Favorable growth in hight salt environment (halophile)
H. salinarium
Why will an increase in temperature decrease the pigment (prodigiosin) that ________ produces?
S. marcescens
proteins denature as temp increases (42 C)
Blood agar test
looking for beta-hemolysis from alpha toxin in staph
Antiseptic
slow down bacteria growth, will not kill them
resistance is rare
Antibiotic
kills bacteria
Resistance is common
Kirby-Bauer method
uses Mueller-Hinton agar
pH 7.2-7.4 (same as human)
incubated at 37 C (same as human)
observe zones of inhibition
Gram negative bacteria in the antimicrobial experiments (Kirby-Bauer method)
E. coli
P. aeruginosa
P. vulgaris
Gram positive bacteria in the antimicrobial experiments
S. aureus (penicillin can’t penetrate peptidoglycan)
Implications of small zone of inhibition
bacteria = resistant, antibacterial not effective
implications of large zone of inhibiiton
bacteria = sensitive, antibacterial was effective
Yogurt fermentation
homolactic fermentation: convert sugars (like glucose) almost exclusively into lactic acid
First step in yogurt fermentation
S. thermophilus ferments lactose to lactic acid (thermophile)
Second step in yogurt fermentation
L. bulgaricus ferments in fridge, provides flavor and aroma (mesophile)
% of staph infections from MRSA
2%
what most staph infections are caused by
S. aureus